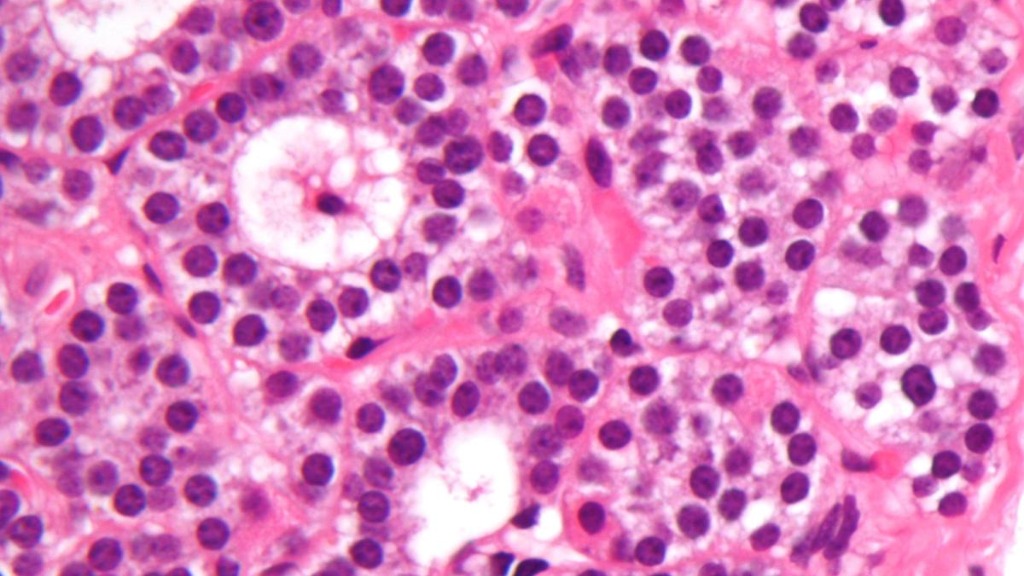

Science Packs
Discover the wonders of biology, chemistry, physics, and beyond.
Biology A
M
Macartney Biology
11 terms
Lora Curll
18 terms

Jim Walker
13 terms
Catherine Stumpf
15 terms
Rachel Simon
20 terms

A
Amanda O'Connell
37 terms
Web of Life
Alexa Godoy (BO)
17 terms
H
Haley Phillips
19 terms
Ms. Becker
16 terms
Chemistry Exams
Adam Thompson
27 terms

J
Jessica Davis
9 terms
Katelyn Graham
7 terms